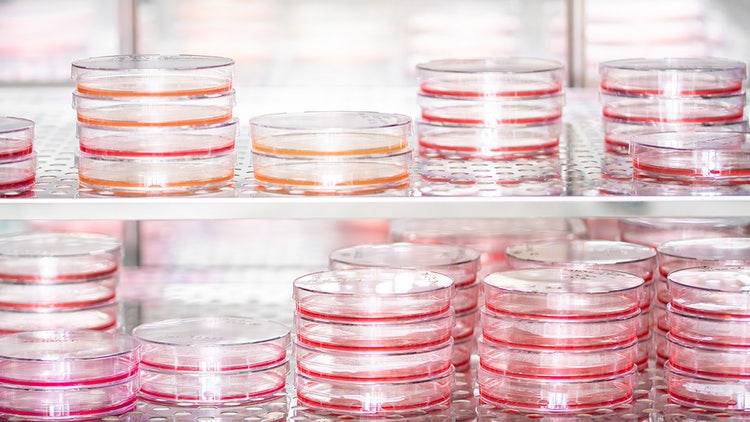
Suspension Cell Culture

Introduction
The world of cell culture offers two primary methods for nurturing these tiny lifeforms: adherent and suspension cultures. Suspension cell culture takes center stage when scientists need to cultivate cells that thrive while floating freely in a liquid environment. By constantly agitating the liquid medium, scientists ensure these free-floating cells, often derived from plants, insects, or specific blood cell types, receive the oxygen and nutrients they need to thrive. This method stands in stark contrast to adherent cultures, where cells establish themselves on a solid surface, replicating and forming a layer.
Suspension cell culture is highly suitable for large-scale biomanufacturing. Compared to adherent cultures, suspension cells tend to have a more homogenous population and can thrive in large bioreactors. This allows for automation of tasks like cell harvesting and nutrient replenishment, leading to meticulous process control, reduced production costs, and enhanced consistency.
Suspension cultures of plant cells facilitate the efficient biosynthesis of secondary metabolites due to their homogeneous growth environment and optimized nutrient supply. Plant cell suspension cultures in bioreactors offer a versatile platform for producing recombinant proteins, enabling controlled and sterile conditions ideal for pharmaceutical applications. Suspension cultures allow for precise manipulation of culture parameters, such as nutrient levels and elicitation strategies, enhancing the production of bioactive compounds and pharmaceutically important proteins. The suspension culture model for 3D tumor modeling utilizes agitation and varying media viscosity to promote cell aggregation into spheroids, facilitating drug screening studies aimed at addressing chemoresistance.
In the sections that follow, we will dive into the core principles of culturing cells in suspension. We'll investigate the upsides and downsides of this approach, discuss its promising uses in biomanufacturing, and look at the latest industry advancements and cutting-edge technologies that are advancing the state-of-the-art in this field.
Propose for the Introduction: The world of cell culture offers two primary methods: adherent and suspension cultures. Suspension culture is particularly advantageous for cultivating cells that proliferate in a liquid environment without needing attachment to a solid substrate. In this approach, the liquid medium is continuously providing optimal distribution of nutrients and gases, particularly oxygen, to cells that remain in suspension. This method of cultivation can be deployed to cells of plant, insect, or hematopoietic origin, which naturally thrive in suspension. In contrast, adherent cultures involve cells anchoring to a substrate, where they proliferate and form monolayers, mimicking in vivo conditions for certain cell types.
Suspension culture systems are particularly well-suited for large-scale biomanufacturing applications. Compared to adherent cultures, suspension cells offer a more homogenous population, are amenable to scaling up in bioreactors, and facilitate automation for key processes such as cell harvesting and nutrient replenishment. This leads to improved process control, lower production costs, and greater consistency in output.
Furthermore, suspension culture systems allow precise manipulation of critical parameters, including nutrient concentrations and elicitation strategies, thereby enhancing the yield of bioactive compounds and therapeutic proteins.
Among cell types used, plant cell suspension cultures, for example, provide an efficient platform for the biosynthesis of secondary metabolites, benefiting from the homogeneous growth environment and controlled nutrient supply. In bioreactor systems, these cultures enable the production of recombinant proteins, co-enzymes, lipids under sterile, regulated conditions, which are crucial for pharmaceutical manufacturing.
The suspension culture model has also been adapted for 3D tumor spheroid formation, where controlled mixing, conditions, and media viscosity are used to promote the aggregation of healthy or cancer cells into spheroids allow researchers to tailor spheroid models to specific research goals, whether that involves studying basic tumor biology, drug screening, or evaluating therapies in a more realistic tumor microenvironment.
In the subsequent sections, we will explore the fundamental principles of suspension cell culture, examine its advantages and limitations, and discuss its applications in biomanufacturing. We will also review recent advancements in technology and methodologies that are driving innovation in this field.
Fundamentals of suspension cell culture
Suspension cell culture offers a unique approach to cultivating cells, distinct from the more common adherent culture method. To understand its intricacies, we must delve into its fundamental aspects:
Types of cells used
Successful implementation of suspension cell culture requires careful selection of the appropriate cell types that thrive in a free-floating environment. Here's a closer look at the common inhabitants of this unique culture system:
- Plant Cells: Many plant cells naturally exist in suspension within plant tissues. This inherent characteristic makes them ideally suited for suspension cultures.
- Insect Cells: Several insect cell lines, particularly those derived from moths (e.g., Sf9 cells ) or fruit flies (e.g., Drosophila S2 cells), are readily grown in suspension.
- Specific Blood Cell Types: While most mammalian cells require adherence for optimal growth, some blood cell types, such as lymphocytes , exhibit a natural affinity for suspension.
- Adapted Mammalian Cell Lines: While suspension culture is not the natural state for most mammalian cells, some established cell lines can be adapted to thrive in this environment.
Culture media and supplements
- Basal medium: There are various types of basal media that is being used for culturing of lymphocytes and hybridomas.
- Serum media: Helps in providing growth factors, hormones, and various other supplements.
Suspension culture media are specially formulated for the chosen cell type, supplying essential nutrients to create a nurturing environment that supports cell growth and function. Let's delve into the key components of a suspension culture medium:
- Basal Salts: These are inorganic salts , often containing essential ions like sodium, potassium, calcium, and magnesium. They play a critical role in maintaining the proper osmotic pressure and pH within the culture medium.
- Sugars: Suspension culture media typically contain a readily available source of glucose to fuel cellular metabolism and support cell growth and proliferation.
- L-Glutamine: An essential amino acid for cell growth and function.
- Non-essential amino acids: Helps reduce the biosynthetic burden on cells.
- Vitamins and Other Growth Factors: These micronutrients play a vital role in various cellular processes. Growth factors are specific to the cell type being cultured, such as cytokines for immune cells or insulin for certain other cells.
Equipment and techniques
Following are some of the specialized equipment and techniques used in suspension culture to maintain a healthy and productive cell population:
-
Bioreactors: These are large, sterile vessels designed to provide a controlled and optimized environment for large-scale cell growth. They typically consist of a stainless-steel tank equipped with various features to ensure optimal cell health:
- Bioreactors employ various agitation systems, such as mechanical stirrers with impellers or rocking platforms, to keep the culture broth constantly mixed. This ensures even distribution of nutrients and gases throughout the culture, preventing cell settling and clumping.
- Bioreactors are equipped with gas exchange systems, often utilizing sparge bars and filters , to allow for the controlled introduction of sterile air or specific gas mixtures.
- Bioreactors possess temperature control systems to maintain the culture at a constant and desired temperature.
- Bioreactors are often equipped with sensors and control systems that continuously monitor critical parameters , such as pH, dissolved oxygen levels, and temperature, and adjust them to maintain optimal growth conditions.
-
Filtration Systems: These are used to separate the cells from the culture medium, providing a sterile and efficient method for cell harvesting. Depending on the specific cell type and desired product, techniques such as tangential flow filtration (TFF) or depth filtration are used.
-
Automated Cell Counters and Viability Assays : These are employed for the regular monitoring of cell health and proliferation rates, ultimately ensuring a productive culture for downstream applications.
-
Aseptic Techniques: Sterile handling procedures and proper use of biosafety cabinets are essential to prevent contamination that could jeopardize the entire culture.
Featured Product
Suspension Cell Culture

Vi-CELL BLU Cell Viability Analyzer
- Fully automated trypan blue dye exclusion method
- High throughput
- 24 position carousel
- Supports 96 well plate
- Faster analysis time compared to Vi-CELL XR
- Single sign-on with Active Directory
- Facilitates 21 CFR Part 11
Advantages and challenges in suspension cell culture
Advantages of suspension cell culture
Suspension cell culture offers several advantages over traditional adherent cell culture, making it a valuable tool for research and biomanufacturing. Here's a breakdown of its key benefits:
- Scalability: Unlike adherent cultures limited by surface area, suspension cultures thrive in large bioreactors, allowing for massive scale-up. This translates to significantly higher yields of the desired product.
- Automation: Tasks like cell harvesting, nutrient replenishment, and environmental monitoring within a bioreactor can be meticulously controlled and automated, reducing production costs and ensuring consistency.
- Homogeneity: Suspension cultures tend to have a more homogeneous cell population compared to adherent cultures, leading to a more predictable and reliable final product.
- Simplified Harvesting: Filtration techniques allow for efficient cell separation from the culture medium, minimizing cell loss and streamlining downstream processing.
- Improved Oxygen Transfer: In suspension cultures, cells are constantly bathed in the culture medium, which facilitates better oxygen transfer throughout the culture.
- Suitability for Specific Cell Types: Certain cell types, like plant cells or specific blood cell types, naturally thrive in suspension. This method offers a unique approach to cultivating these cells for research and production purposes.
Common challenges and solutions
Despite its well-documented advantages, suspension cell culture is not without its challenges. Here's a closer look at some of these hurdles and potential solutions that can be implemented:
- Shear Stress: Agitation, necessary to keep cells suspended, can generate shear stress, potentially damaging delicate cells.
- Solution: Agitation speed and impeller design can be optimized to minimize shear forces. Gentle mixing techniques, like rocking platforms , can be utilized for shear-sensitive cells.
- Nutrient and Gas Availability: Ensuring the even distribution of nutrients and gases throughout a large bioreactor can be challenging.
- Solution: Efficient agitation systems can be employed, and bioreactor design can be optimized for optimal mixing and gas exchange. Additionally, computer modeling can be used to simulate and optimize flow patterns within the bioreactor.
- Foam Formation: During agitation, foaming can occur, hindering gas exchange and potentially impacting cell viability.
- Solution: Antifoaming agents can be included in the culture media at minimal concentrations to prevent foam formation without compromising cell health.
- Contamination Risk: Maintaining sterility in large bioreactors is crucial, but contamination events can occur.
- Solution: Rigorous aseptic techniques can be implemented throughout the culture process. Additionally, bioreactor features like sterilization-in-place (SIP) systems and continuous monitoring for potential contamination can be utilized.
- Monitoring and Control: Maintaining optimal culture conditions in a large bioreactor requires robust monitoring and control systems.
- Solution: Investment can be made in reliable sensors and control systems for real-time monitoring of critical parameters like pH, temperature, and dissolved oxygen. Automated feedback mechanisms can be utilized to adjust parameters as needed.
- Cell Aggregation: While agitation prevents settling, excessive cell-cell contact can lead to clumping and hinder nutrient and oxygen exchange.
- Solution: Culture conditions, including media composition and agitation settings, can be optimized to minimize cell aggregation. In specific situations, the utilization of anti-clumping agents can be considered.
Suspension cell culture applications in biomanufacturing
Suspension cell culture plays a vital role in modern biomanufacturing, particularly in the production of biologics, vaccines, and viral vectors. Here's a closer look at its specific applications in these areas:
- Biologics Production: Suspension cultures excel in the cost-effective production of large quantities of various therapeutic proteins . Examples include monoclonal antibodies for cancer treatment, erythropoietin for treating anemia, and insulin for diabetes. Their ability to fine-tune culture conditions also allows for the optimized expression of recombinant proteins in the cultured cells.
- Vaccine Development: Suspension cultures offer a platform for the large-scale production of attenuated or inactivated viruses used in vaccines . They can also be used to efficiently produce subunit vaccines containing specific protein antigens from a pathogen.
- Viral Vector Manufacturing: Suspension cultures offer a scalable method for growing and amplifying viral vectors used in gene therapy for diseases like cystic fibrosis or hemophilia. Additionally, they can be employed for large-scale production of oncolytic viruses, providing a promising approach for cancer treatment.
Featured Product

CellXpress.ai Automated Cell Culture System
The future of cell culture backed by machine learning and data-driven science.
Suspension cell culture trends
The field of suspension cell culture is constantly evolving, driven by advancements in technology and a growing demand for efficient biomanufacturing processes. Here's a glimpse into some of the exciting trends and developments pushing the boundaries:
- Perfusion Culture Systems: Traditional suspension cultures operate in a batch mode, where nutrients are depleted over time. Perfusion systems offer a continuous flow of fresh media and the removal of waste products, leading to higher cell densities and increased product yields.
- Single-Use Bioreactors: Disposable bioreactors eliminate the need for sterilization cycles between cultures, reducing costs and turnaround times. This technology is particularly appealing for clinical-grade biomanufacturing.
- Computational Modeling and Process Optimization: Computer simulations can be used to model and optimize bioreactor design , agitation strategies, and nutrient delivery. This in silico approach helps to streamline culture processes and identify potential bottlenecks before large-scale production.
- Integration with Automation and Robotics: Automation is playing a growing role in managing various aspects of suspension cultures , from cell seeding and harvesting to data analysis. This reduces human error, prevents contamination, and ensures consistent production across batches.
- Microfluidic Technologies: Microfluidic devices offer a miniaturized platform for culturing cells. These devices allow for precise control over the microenvironment and have potential applications in high-throughput screening and personalized medicine.
- Co-Culture Systems: Introducing multiple cell types into a single suspension culture can mimic the complexity of natural tissues. This approach has potential applications in drug discovery and the development of more advanced cell therapies.
Conclusion
In conclusion, suspension cell culture has emerged as a powerful tool, transforming the biomanufacturing landscape with its scalability, efficiency, and suitability for specific cell types. While challenges remain, ongoing advancements in technology and a deeper understanding of cell culture processes are continuously pushing the boundaries of this technique. These advancements promise even greater efficiency and cost-effectiveness in biomanufacturing, ultimately contributing to the development of life-saving therapies and propelling the field of biomedicine forward.
See how Danaher Life Sciences can help
FAQs
How is suspension cell culture different from adherent cell culture?
Suspension cell culture is for cultivating cells that thrive while floating freely in a liquid environment. This method stands in stark contrast to adherent cultures, where cells establish themselves on a solid surface, replicating and forming a layer.
What are the advantages of suspension cell culture over adherent cell culture?
- Unlike adherent cultures limited by surface area, suspension cells can flourish in massive bioreactors, yielding significantly higher quantities of the desired product.
- The entire process within a bioreactor can be meticulously controlled and automated, streamlining tasks like cell harvesting and nutrient replenishment. This translates to reduced production costs and enhanced consistency.
- Suspension cultures tend to have a more homogenous cell population compared to adherent cultures. This uniformity leads to a more predictable and reliable final product, making suspension cell culture a game-changer in large-scale biomanufacturing.
What are the common challenges faced in suspension cell culture?
- Shear stress: Agitation can damage delicate cells.
- Nutrient/gas limitations: Ensuring even distribution in large cultures.
- Foam formation: Can hinder gas exchange and cell viability.
- Contamination risk: Maintaining sterility in large bioreactors.
- Cell aggregation: Excessive clumping can hinder nutrient/oxygen exchange.
What equipment is needed for suspension cell culture?
- Bioreactors or flasks for shaking: To keep cells in suspension.
- Incubator: To maintain optimal temperature.
- Sterile culture supplies: Pipettes, tubes, flasks, etc.
- Monitoring equipment: For pH, dissolved oxygen, etc.
- Cell proliferation & cell morphology
- Nutrient and metabolites measurement
- Sterility testing